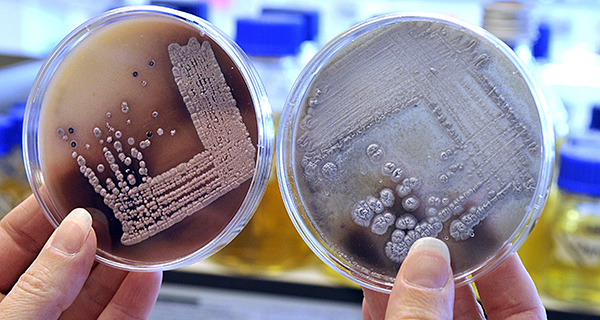

Wetenschappelijke ontwikkelingen doen zich voor op vlakken waar verschillende onderzoeksvelden elkaar raken: van biotechnologisch onderzoek tot samenwerking op het gebied van vergrijzing. Binnen de RUG is onderzoek onderverdeeld in drie interdisciplinaire onderzoeksclusters: Healthy Ageing, Energy en Sustainable Society. Zowel binnen als buiten de RUG zijn we intensieve samenwerkingsverbanden aangegaan, waarbij we de doelstellingen van het Europese Horizon 2020-programma sterk in het vizier houden.